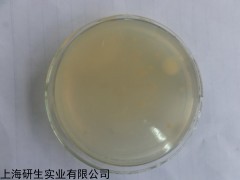

| 提交询价信息 |
| 发布紧急求购 |

价格:电议
所在地:上海
型号:
更新时间:2018-12-14
浏览次数:932
公司地址:上海市漕宝路66号20F
![]()
刘小姐(女士)
中文名称:多粘菌素B(2.25万单位)品牌
英文名称:
产品规格: 2.25万单位*5支
产品用途: 每支添加于225ml胰酪胨大豆多粘菌素肉汤基础中

每支添加于225ml胰酪胨大豆多粘菌素肉汤基础中
多粘菌素B(2.25万单位)品牌的步骤:
(一)准确称量试剂:根据不同的菌类和用途,选择适宜的培养基,培养基所需试剂必须纯净。
(二)校正pH值:将称量好的培养基各种成分放入容器内,标记划线,加热溶解,补充水分,测定酸碱度,常用pH6.8~8.0的试纸或酸度计测定。用1N NaOH和1N HCl调节pH值到适宜范围内。
(三)过滤:将玻璃漏斗置铁架上,再用纱布夹棉花或用滤纸放在漏斗中,将上述培养基倒入其中过滤至透明。
(四)分装:将过滤后的培养基分装于中试管或三角瓶内(试管内每支装5mL;三角瓶中装100~150ml),塞好棉塞用牛皮纸包扎好,准备灭菌。
(五)灭菌:培养基的灭菌,常用高压蒸汽灭菌法。一般微生物的营养细胞在水中煮沸后即被杀死,但细菌的芽胞有较强的抗热性,须经高压蒸汽灭菌才能达到彻底灭菌的目的。根据蒸汽温度随压力升高而上升的原理,即压力越大,蒸汽温度就越高。因此,在同一温度条件下,采用高压蒸汽灭菌比干热灭菌法效果要好。而且在湿热情况下,菌体吸收水分后,其蛋白质易于凝固变性,因为蒸汽的穿透力强,杀菌效果好。
多粘菌素B(2.25万单位)品牌注意事项
1.使用琼脂糖需要加温,请做好必要的防护措施,避免烫伤。
2.强烈建议您不要将琼脂糖粉末直接倒入沸水中,这样做会引起爆沸,溅出,致使浓度下降,还会造成结块而融化困难。正确的做法是称量一定量琼脂糖至三角瓶中,根据配制浓度加入一定量的缓冲液(与电泳缓冲液一致),加盖硅胶塞(防止温度差别造成表面结膜),微波或其他方式加热至沸腾2分钟左右,戴手套小心取出,摇匀,使之完全溶解。
3.必须保证琼脂糖完全溶解,否则造成电泳条带不清,保证完全溶解的前提下,尽量缩短加热时间。
公司培养基系列产品都经过质量体系安全验证,从生产到销售都经过严格把关确保质量合格后方可出售,多粘菌素B(2.25万单位)品牌包装完好,内附检验报告。
2,5-二氯-4- 405230-82-2
2,6-二氨基-3-氰基-4-甲基吡啶 38841-52-0
4-氨基-3,5-二氯-2,6-二氟吡啶 2840-00-8
3,5-二氯-2,6-二氟嘧啶 698-51-1
2,6-二氟-3-氯吡啶 52208-56-7
4-氨基-2,6-二氟吡啶 63489-58-7
2,6-二氟-4-羟基苯甲酸 214917-68-7
1,2,3,4-四氢丫啶 3295-64-5
2,6-二氮杂螺[4.4]壬烷-2-羧酸叔丁酯 646055-63-2
1,7-二氯异喹啉 70810-24-1
1,8-萘啶 254-60-4
4-溴-1-氯异喹啉 66728-98-1
5-溴-1-氯异喹啉 34551-41-2
1-氯-6-溴异喹啉 205055-63-6
1-氯-8-溴异喹啉 1233025-78-9
N-(3-甲酰基-2-吡啶基)-2,2-甲基丙酰胺 86847-64-5
2,6-二氯喹啉 1810-72-6
3-氰基-2,6-二羟基-4-三氟甲基吡啶 3335-46-4
2,3,4,5-四氟吡啶 3512-16-1
2,3,4 ,5-四氯吡啶 2808-86-8
2,3,5,6-四氟吡啶 2875-18-5
2,3,5,6-四氯4- 2176-63-8
二(4-联苯基)胺 102113-98-4
4-硼酸三苯胺 201802-67-7
三(4-碘苯)胺 4181-20-8
4-(二甲苯基胺)苯甲醛 332411-18-4
4-(3,5-二溴苯基)-2,6-二苯基嘧啶 607740-08-9
Phellodendrine
Phellodendrine chloride
Tetrahydroberberine
多粘菌素B(2.25万单位)品牌Sophoricoside
Sophocarpine
Troxerutin
β-Ecdysone
3-Acetoxy-5-methoxystilbene
3-O-Acetylpinobanksin
5-Acetoxy-7-hydroxyflavone
Acetylisocupressic acid
Agathadiol diacetate
3,7-Di-O-acetylpinobanksin
5,7-Diacetoxyflavone
Dihydropinosylvin
Dihydropinosylvin methyl ether
12-Hydroxyabietic acid
5-Hydroxy-7-acetoxyflavone
Isocupressic acid
Pinobanksin
Pinocembrin 7-acetate
Pinocembrin diacetate
Pinostilbene
Pinosylvin
Pinosylvin mo
Pinusolidic acid
Serratenediol diacetate
Chinensine B
Coro
多粘菌素B(2.25万单位)品牌(一)一般按照培养基物理分类可分为:
(1)液体培养基:类配制成的液体状态的基质。(2)固体培养基:一类配制成的固体状态的基质,根据性质又分为固化培养基、非可逆性固化培养基、天然固态培养基、滤膜。(3)半固体培养基:指在液体培养基中加入少量的凝固剂而配制成的半固体状态的培养基。(4)脱水培养基:又称预制干燥培养基,指含有除水分外的一切成分的商品培养基。
(二)外周血培养基配制:
一、配制用水
培养基的大部分是水,所以水的质量直接影响产品名称的质量。按Waymouth标准,水的电阻应为200万欧姆,一般实验室里以玻璃蒸馏器制备的
双蒸水或三蒸水可以符合使用条件。
 免责声明:以上所展示的[ 多粘菌素B(2.25万单位)品牌]信息由会员[上海研生实业有限公司]自行提供,内容的真实性、准确性和合法性由发布会员负责。
免责声明:以上所展示的[ 多粘菌素B(2.25万单位)品牌]信息由会员[上海研生实业有限公司]自行提供,内容的真实性、准确性和合法性由发布会员负责。